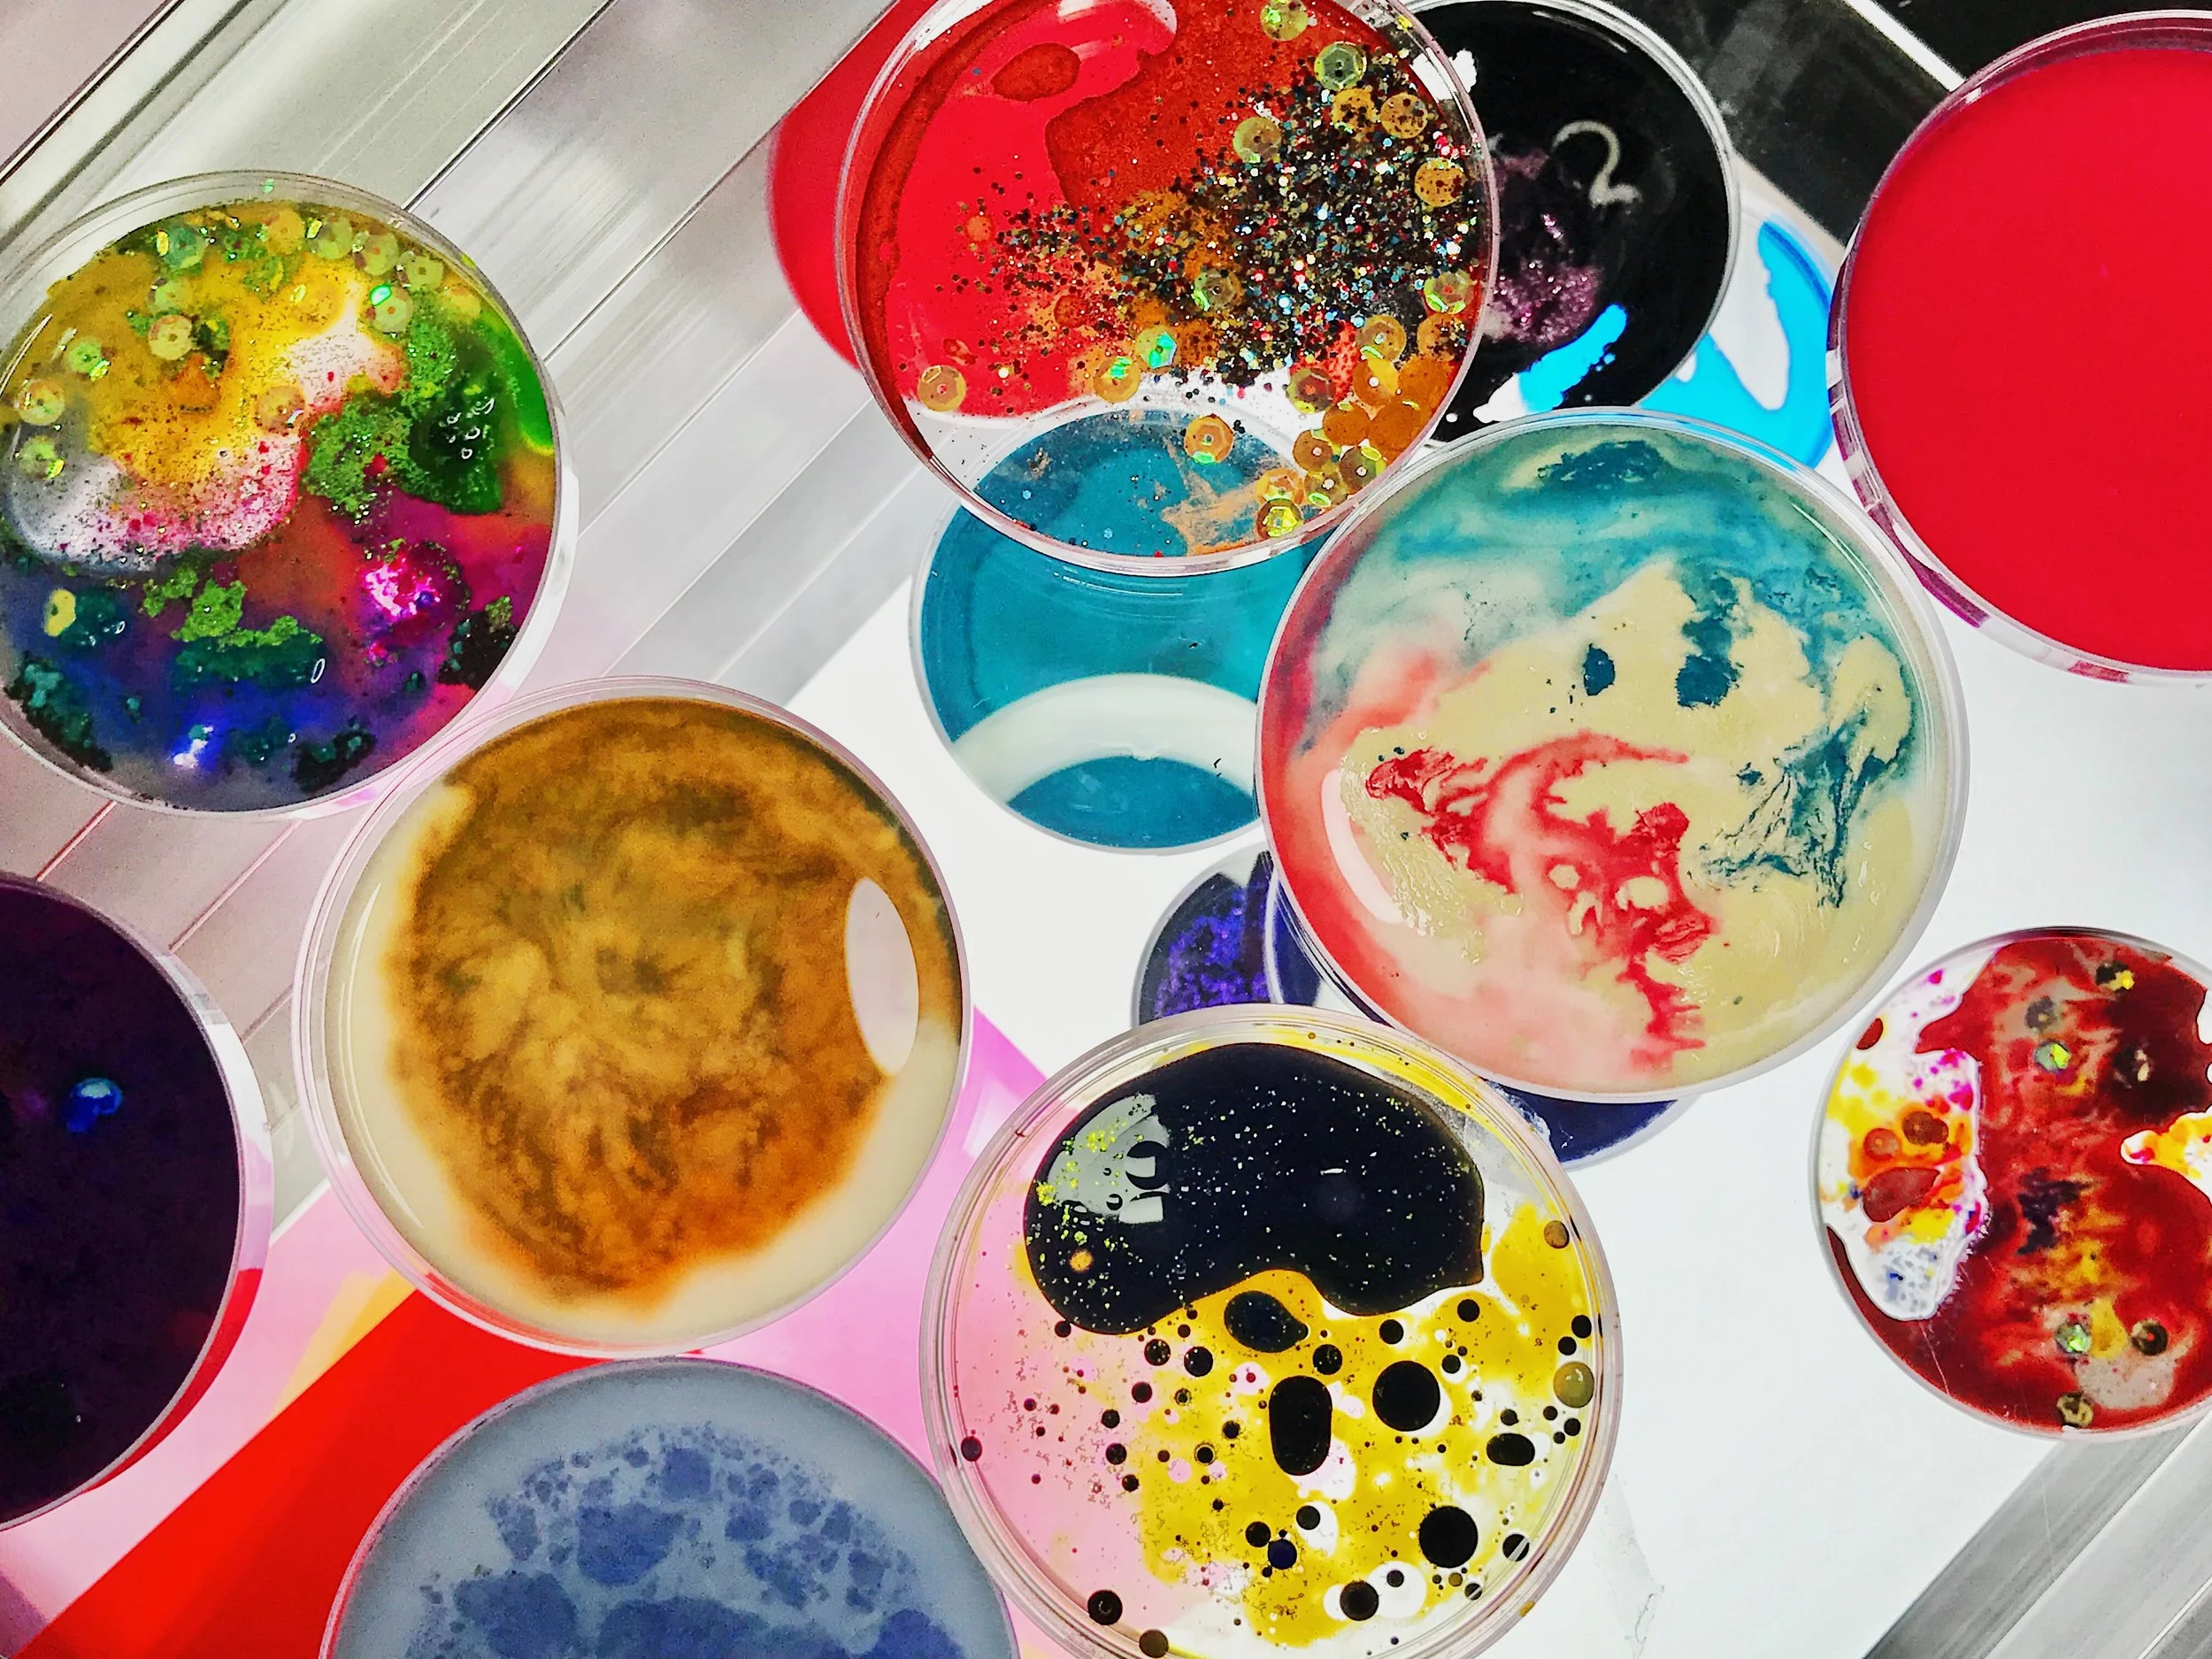

Joined VSCO’s Come Closer New York workshop
Come Closer New York workshop at 263 Bowery Street New York, NY 10002. (All photos were taken with iPhone 7 Plus)
I was invited by VSCO (Visual Supply Company) to join their unique workshop in Bowery, Manhattan last Saturday.
VSCO has been a very popular image editing app on smarphones past 7 years, and this time, they built a pop-up gallery in NY alongside the forthcoming New York Fashion Week.
Use The Street Style Series (SS1-SS3) and post your images with #VSCONewYork for a chance to be displayed here! (until Feb. 16th, 2019)
Quite frankly, what I actually did at the workshop was to take a science/recreation class for the first time in 15+ years! Honestly I expected to see a lot of photos displayed in the gallery, but it was fun to create something like a kid :-)
Looks like a science room.
So many colors to play with.
Started to make my own artwork like this.
It was a mixture of blue and yellow dots but they were completely mixed and turned to be green while I was carrying the plate to the photo booth. oops!
Other guest’s work. Nice.
Got a nice VSCO tote bag with VSCO logo pin badge.
In the tote bag, there was another nice gift, slide loupe. By the way, we could make our own pin badges out of our experimental work. The green turned much dull sadly but I really enjoyed the workshop. Thanks VSCO ;-)